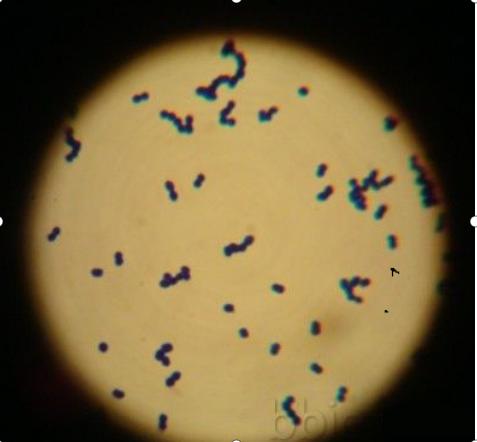
肠球菌在什么情况下会长,肠球菌到底是什么

肠球菌最初从人的大便里分离得到,由于它的样子与链球菌相似,很长一段时间都被称为肠链球菌,可是后来人们慢慢发现它与链球菌有着很大的不同,所以现在将其单独命名为肠球菌属。肠球菌本是人和动物肠道的正常菌群之一,在健康人大便里含有大量的肠球菌,大概每1克粪便就有上百个肠球菌,不仅是肠道,人的口腔、胆囊、女性生殖道也常有该菌存在。这些肠球菌可以帮助我们发酵糖类,产生乳酸,分解蛋白质以助于消化,并且参与营养代谢。另外它还能产生一些抗菌物质,抑制有害细菌生长,保护肠道黏膜。我们日常吃的酸奶里就常常发现它的存在,从这一方面说,肠球菌对人类还是有有益的一面。
但事情往往具有两面性,肠球菌也不例外,一旦条件成熟,它就会变成致病菌,比如过量使用抗生素造成肠道菌群失调,从而使肠球菌大量繁殖,一旦超过人体承受的范围,它就会在粘附素的作用下粘附到人体细胞上,进而分泌细胞溶解素、明胶酶等一系列毒力因子来破坏正常组织,引发感染。
在肠球菌家族中有两种肠球菌,分别是粪肠球菌和屎肠球菌最为常见。粪肠球菌和屎肠球菌虽然只有一字之差,但却是两种不同的细菌。粪肠球菌在临床上引起的感染更多见,比如尿路感染、腹腔盆腔感染、败血症中都有它的踪迹;但是屎肠球菌比起粪肠球菌其耐药性更强,一旦感染,治疗难度会更大。
说起肠球菌的耐药性,着实是让临床医生头疼的一件事。肠球菌由于长期在人体的肠道中生存,面对肠道复杂的环境,它早就有了很强的适应能力,也就产生了很强的抵抗性,我们常用的青霉素、头孢菌素、庆大霉素等都很难轻易地消灭它,就连非常高级的万古霉素对有些耐药性强的肠球菌都无能为力,这让临床在治疗感染时变得非常棘手,往往需要多种抗生素联合应用才能有效地杀死它。
最后,需要我们注意的是,肠球菌的抵抗力相对于其他细菌来说是比较强的,所以需要我们特别注意,不要吃不洁净的食物,饭前便后一定要洗手。不过好在这些耐药性强的肠球菌主要在医院里面存在,日常生活中还是不容易接触到的,只要我们保持良好的个人卫生,不要稍有不适就乱用抗生素,就可以避免被肠球菌感染。